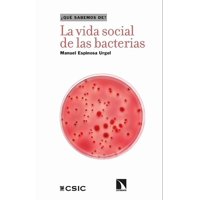
Océano - Libro La Vida Social De Las Bacterias Un Viaje Al Mundo D

Santillana
Santillana - La Metamorfosis De Aurora Un Viaje Con Las Mariposas De Chile | Lider Electrohogar
Precio: $ 15.070
Visitar Lider Electrohogar
Prueba buscando otros productos en:
Historial de precios
Fecha
29 Ene
Precio
$ 15.070
Santillana - La Metamorfosis De Aurora Un Viaje Con Las Mariposas De Chile | Lider Electrohogar
$ 15.070
Visitar Lider Electrohogar
Características técnicas
Marca
Santillana
Descripción
Mekis catalina medina maría de los ángeles
Marca
Santillana
Descripción
Mekis catalina medina maría de los ángeles
Prueba buscando otros productos en:
Productos relacionados
Crossbooks Chile
Crossbooks Chile - Libro La Vida De Las Marionetas
$ 16.990
$ 17.790
4%de aumento.
Océano
Océano - Libro La Vida Social De Las Bacterias Un Viaje Al Mundo D
$ 14.816
$ 15.802
6%de aumento.
Planetalector Chile
Planetalector Chile - Libro Acira, La Niña De Las Arenas
$ 7.225
$ 8.211
13%de aumento.
Dk
Dk - Las Mariposas De Mi Jardin
$ 15.300
$ 16.286
6%de aumento.
Santillana
Santillana - Caminos De La Fe 5 Básico
$ 26.724
$ 31.483
17%de aumento.
Planeta
Planeta - Libro El Secreto De Las Mariposas
$ 11.290
$ 11.990
6%de aumento.
Santillana
Santillana - Dioses Y Héroes De La Mitología Griega
$ 12.142
$ 12.894
6%de aumento.
Peninsula Chile
Peninsula Chile - Libro La Historia Del Mundo. Un Atlas
$ 16.390
$ 17.790
8%de aumento.
Todo Hogar Santiago De Chile
Todo Hogar Santiago De Chile - Set De 4 Mariposas - Blanco
$ 28.990
Planetalector Chile
Planetalector Chile - Libro Las Contadoras De Estrellas
$ 10.965
$ 10.590
3%de descuento.
F
Bolso de viaje con ruedas Kross M 89 lts azul F la Maleta de Chile
$ 39.990
$ 47.990
20%de aumento.
F
Bolso de viaje con ruedas Kross L 131 lts rojo F la Maleta de Chile
$ 37.990
$ 39.990
5%de aumento.